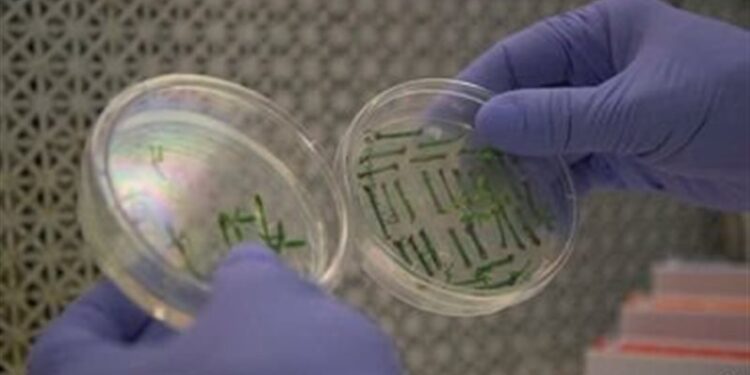
تخليـــق نماذج لأجنة بشرية دون بويضات وحيوانات منوية

حرية – (15/6/2023)
اشترك في قناة حرية الاخبارية على التيليكًرام ليصلك كل جديد
ابتكر فريق من الباحثين في الولايات المتحدة والمملكة المتحدة، أول هياكل شبيهة بالأجنة البشرية الاصطناعية في العالم من الخلايا الجذعية، متجاوزين الحاجة إلى البويضات والحيوانات المنوية، وفقا لشبكة “سي أن أن”.
وأوضحت الشبكة في تقرير، الأربعاء، أن هذه الهياكل الشبيهة بالجنين لا تزال في المراحل الأولى جدا من التطور البشري، وعلى سبيل المثال ليس لديهم قلب أو دماغ نابض.
لكن العلماء يقولون إنهم قد يساعدون يوما ما في تعزيز فهم الأمراض الوراثية أو أسباب الإجهاض.
ووفقا للشبكة، يثير البحث أسئلة قانونية وأخلاقية مهمة، ولا يوجد لدى العديد من البلدان، بما في ذلك الولايات المتحدة، قوانين تنظم إنشاء أو معالجة الأجنة الاصطناعية.
ويأمل الباحثون، بحسب الشبكة، أن تلقي هذه الأجنة النموذجية الضوء على “الصندوق الأسود” للتطور البشري، في الفترة التي تلي 14 يوما بعد الإخصاب، وهو الحد المتفق عليه لدى العلماء لنمو الأجنة ودراستها في المختبر.
وذكرت صحيفة “ذا جارديان”، الأربعاء، أنه لا يوجد احتمال قريب المدى لاستخدام الأجنة الاصطناعية سريريا. وسيكون من غير القانوني زرعها في رحم المريض، خاصة أنه لم يتضح بعد ما إذا كانت هذه الهياكل لديها القدرة على الاستمرار في الحياة إلى ما بعد المراحل الأولى من التطور.
وأوضحت الصحيفة أن الأبحاث التي أجريت على الحيوانات باستخدام الخلايا الجذعية من الفئران والقرود أظهرت أنه حتى عندما حاول العلماء زرعها، فإنها لا تعيش، ربما لأن الباحثين لم يكتشفوا كيفية القيام بذلك بشكل كامل.
وأشارت إلى أن هذا التطور يسلط الضوء على مدى سرعة تفوق العلم في هذا المجال، ويتحرك العلماء في المملكة المتحدة وأماكن أخرى بالفعل لوضع مبادئ توجيهية للتحكم في العمل على الأجنة الاصطناعية.